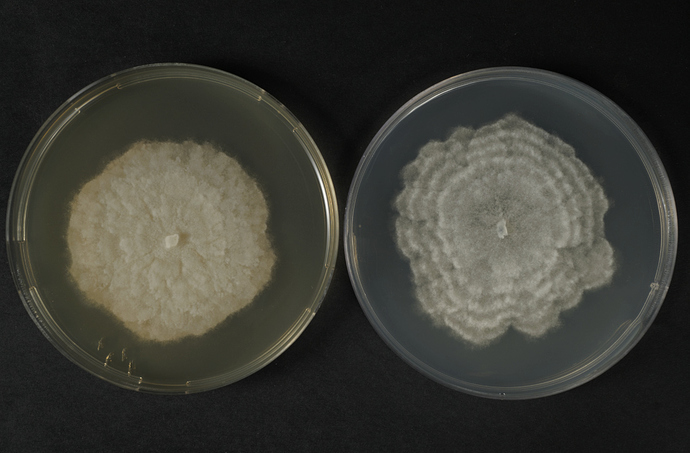

Hello @Thanatomanic
Do you need to inspect the plants for the progression of their disease? Is color accuracy important? If so, have you photographed a color target
Our Italian public laboratory receives every year hundreds of samples with some unknown plant disease, mostly fungi, bacteria, viruses, nematodes and we are supposed to discover what is the “killer” (culprit) of these plants.
As a result, I am charged to keep track, as a photographer, of these samples even though my real day job concerns plant pathology, not photography 
In the past, I did have tried a X-Rite color checker but in the end, at least on my display of course, I have realized it was not completely necessary because the colours were pretty much accurate out of the box when I displayed the Raw files on my display with RawTherapee (Amaze method together with the standards settings) or other “similar” softwares (Windows 10 as system).
With a thermo colorimeter tool a colleague of mine measured the Kelvin light (temperature) of our Elinchrom lamp and he suggested me to always set accordingly my Nikon D700 with 2850 kelvin (manual white balance) which I duly do 
I keep the ISO as low as possible (usually 200) and I never take my picture with a very closed diafram (usually F8 - F9, as the uppermost closure).
The Nikon D700 is always mounted on a tripod and it is over my samples.
I have only always used a lamp so far (which is on my right) because, on the left (opposite to it), I have got a white sheet of paper to reduce the shadows of the samples (which lies in the middle of this setup). Quite often I replace the white sheet with a plastic panel (30x50 cm) with a “Silver” coat on it to decrease even further the shadows generated by my samples with the supplementar advantage of illuminating the sample on its left side.
BTW, in front of the lamp there is a huge “semi-transparent” sheet of paper to reduce the strenght of the light generated by this lamp.
Sorry but my technical English is not good enough to describe these tools exactly…
And yep, colour accuracy is KEY for my pictures (together with sharpness) 
EDIT: if you take a closer look at the white dish (the one on the right of the first picture) you can easily spot the shadows generated both by the other near dish (the one on the left) and by the panel itelf (its effect is even more marked on this white petri dish).
Therefore, this picture would be extremely time-tasking to correct as regards the enhancing of the colours of the light yellow bacteria (Xanthomonas species ) growing on the right white petri dish and the shadows on it (which are visible as “half-circles” on its white surface).
To make it short, I should have paid much more attention when I have shot it